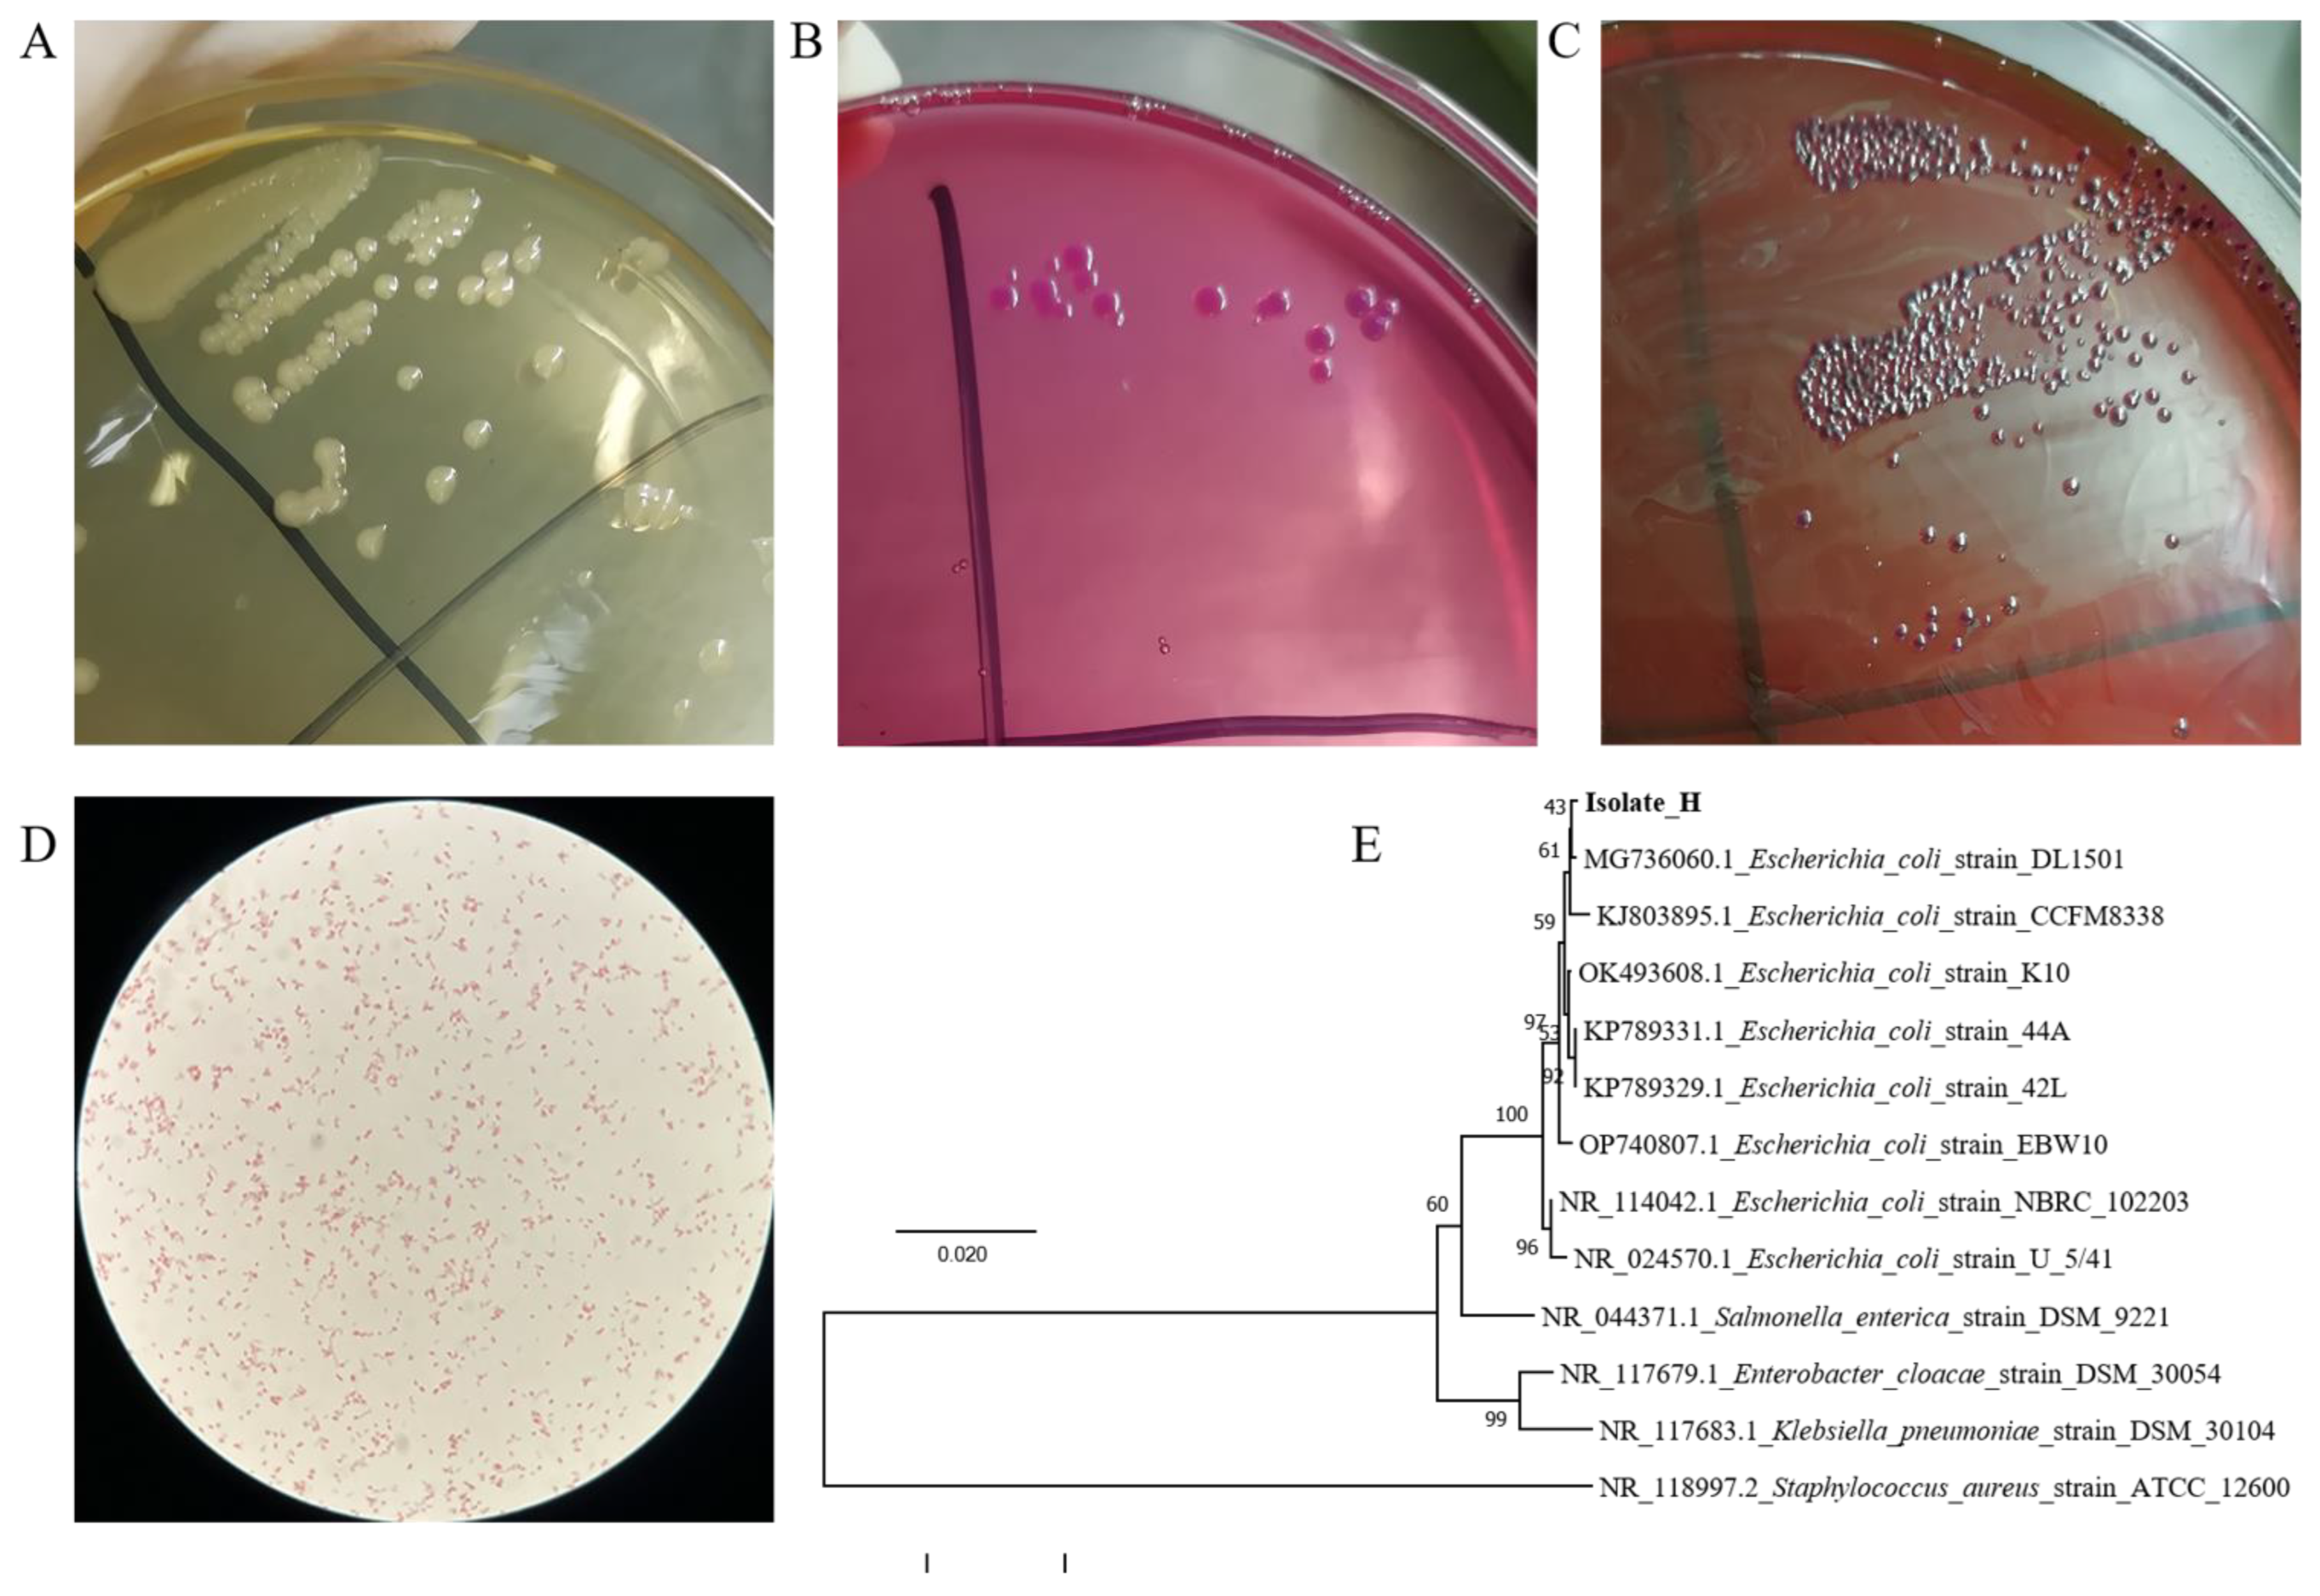
Vetsci 10 00328 g001 Vetsci 10 00328 g001

Bacteriostatic Effects of Yujin Powder and Its Components on Clinical Isolation of Multidrug-Resistant Avian Pathogenic Escherichia coli
Abstract
Simple Summary
Abstract
1. Introduction
2. Materials and Methods
2.1. Bacterial Strains
2.2. Isolation and Identification of the Pathogen
2.3. Antimicrobial Susceptibility Testing
2.4. Drug Extracting Methods
2.5. The MICs of YJP and Its Components
2.6. Compliance with Ethical Standards
2.7. YJP and Its Components against MDREC In Vivo
2.8. Histopathological Evaluation
2.9. Bacterial Loads in Organs
2.10. Endotoxin and Indexes of Inflammatory
2.11. Statistical Analysis
3. Results
3.1. The Colony Morphology of the Isolate
3.2. Biochemical Identification of the Isolate
3.3. Microscopic Identification and PCR Identification
3.4. Antimicrobial Susceptibility Testing
3.5. Antimicrobial Activity of CIP, YJP, and Its Components
3.6. The Survival Rate of Each Group of Infected Mice
3.7. Histopathological Changes of the Spleen of Mice
3.8. Bacteria Loads in Various Organs of Mice
3.9. Assessment of Inflammatory Cytokines Levels
3.10. The Levels of Bacterial Endotoxin in Serum
4. Discussion
5. Conclusions
Supplementary Materials
Author Contributions
Funding
Institutional Review Board Statement
Informed Consent Statement
Data Availability Statement
Acknowledgments
Conflicts of Interest
Abbreviation
| YJP | Yujin powder |
| SR | Scutellariae Radix |
| Rb | Rhubarb |
| Bac | Baicalin |
| CIP | Ciprofloxacin |
| APEC | Avian pathogenic Escherichia coli |
| MDREC | Multi-drug-resistant E. coli |
| MIC | Minimum inhibitory concentration |
| TCM | Traditional Chinese medicine |
| TCVM | Traditional Chinese veterinary medicine |
| CLSI | Clinical and Laboratory Standards Institute |
References
- Kathayat, D.; Lokesh, D.; Ranjit, S.; Rajashekara, G. Avian Pathogenic Escherichia coli (APEC): An Overview of Virulence and Pathogenesis Factors, Zoonotic Potential, and Control Strategies. Pathogens 2021, 12, 467. [Google Scholar] [CrossRef] [PubMed]
- Newman, D.M.; Barbieri, N.L.; de Oliveira, A.L.; Willis, D.; Nolan, L.K.; Logue, C.M. Characterizing avian pathogenic Escherichia coli (APEC) from colibacillosis cases, 2018. PeerJ 2021, 9, e11025. [Google Scholar] [CrossRef]
- Zhuang, Q.Y.; Wang, S.C.; Li, J.P.; Liu, D.; Liu, S.; Jiang, W.M.; Chen, J.M. A clinical survey of common avian infectious diseases in China. Avian Dis. 2014, 58, 297–302. [Google Scholar] [CrossRef] [PubMed]
- Bacanli, M.; Basaran, N. Importance of antibiotic residues in animal food. Food Chem. Toxicol. 2019, 125, 462–466. [Google Scholar] [CrossRef] [PubMed]
- Costa, M.C.; Bessegatto, J.A.; Alfieri, A.A.; Weese, J.S.; Filho, J.A.; Oba, A. Different antibiotic growth promoters induce specific changes in the cecal microbiota membership of broiler chicken. PLoS ONE 2017, 12, e171642. [Google Scholar] [CrossRef]
- Lobanovska, M.; Pilla, G. Penicillin’s Discovery and Antibiotic Resistance: Lessons for the Future? Yale J. Biol. Med. 2017, 90, 135–145. [Google Scholar]
- Muurinen, J.; Richert, J.; Wickware, C.L.; Richert, B.; Johnson, T.A. Swine growth promotion with antibiotics or alternatives can increase antibiotic resistance gene mobility potential. Sci. Rep. 2021, 11, 5485. [Google Scholar] [CrossRef]
- Xu, X.; Sun, Q.; Zhao, L. Virulence Factors and Antibiotic Resistance of Avian Pathogenic Escherichia coli in Eastern China. J. Vet. Res. 2019, 63, 317–320. [Google Scholar] [CrossRef]
- Gao, J.; Duan, X.; Li, X.; Cao, H.; Wang, Y.; Zheng, S.J. Emerging of a highly pathogenic and multi-drug resistant strain of Escherichia coli causing an outbreak of colibacillosis in chickens. Infect. Genet. Evol. J. Mol. Epidemiol. Evol. Genet. Infect. Dis. 2018, 65, 392–398. [Google Scholar] [CrossRef]
- Yoon, M.Y.; Kim, Y.B.; Ha, J.S.; Seo, K.W.; Noh, E.B.; Son, S.H.; Lee, Y.J. Molecular characteristics of fluoroquinolone-resistant avian pathogenic Escherichia coli isolated from broiler chickens. Poult. Sci. 2020, 99, 3628–3636. [Google Scholar] [CrossRef]
- Guo, Y.; Li, J.X.; Wang, Y.L.; Mao, T.Y.; Chen, C.; Xie, T.H.; Han, Y.F.; Tan, X.; Han, H.X. Yinchen Linggui Zhugan Decoction Ameliorates Nonalcoholic Fatty Liver Disease in Rats by Regulating the Nrf2/ARE Signaling Pathway. Evid. Based Complement. Altern. Med. 2017, 2017, 6178358. [Google Scholar] [CrossRef] [PubMed]
- Tao, Y.; Li, C.; Gao, T.; Huo, J. Molecular mechanism of Sishen pills in the treatment of diarrheal diabetic enteropathy based on network pharmacology. Medicine 2022, 101, e30096. [Google Scholar] [CrossRef] [PubMed]
- Yao, W.; Yang, C.; Wen, Y.; Zhang, W.; Zhang, X.; Ma, Q.; Ji, P.; Hua, Y.; Wei, Y. Treatment effects and mechanisms of Yujin Powder on rat model of large intestine dampness-heat syndrome. J. Ethnopharmacol. 2017, 202, 265–280. [Google Scholar] [CrossRef]
- Yao, W.; Zhang, Y.; Zhang, W.; Wen, Y.; Yang, R.; Dong, J.; Zhang, X.; Hua, Y.; Ji, P.; Wei, Y. Pathological mechanism of intestinal mucosal barrier injury of large intestine dampness-heat syndrome rats and the protective effect of Yujin powder. Res. Vet. Sci. 2022, 152, 485–496. [Google Scholar] [CrossRef] [PubMed]
- Song, C.; Ji, M.; Xu, J.; Huo, B.; Chi, Y.; Shen, X. Study on the Therapeutic Effect of Modified Yujin Powder on Transimmissible Gastroenteritis in Landrace Pigs. China Anim. Husb. Vet. Med. 2019, 46, 600–607. [Google Scholar]
- Yu, B.; Yu, Y. Yuan Heng’s Classical Collection on the Treatment of Equine Diseases; Agriculture Press: Beijing, China, 1957; p. 138. (In Chinese) [Google Scholar]
- Chinese Veterinary Pharmacopoeia Commission. Veterinary Pharmacopoeia of People’s Republic of China; Chinese Agriculture Press: Beijing, China, 2020; Volume II. (In Chinese) [Google Scholar]
- Wang., D. Practical Chinese Veterinary Medicine, 1st ed.; Chinese Agriculture University Press: Beijing, China, 2006; p. 68. (In Chinese) [Google Scholar]
- Zhang, Y.; Yao, W.; Wen, Y.; Wen, Y.; Hua, Y.; Peng, J.; Wei, Y. Regulation of Yujin Powder on Serum Immunoglobulin and Antioxidant Related Factors of Large Intestine Dampness-heat Syndrome Rat. Chin. J. Anim. Vet. Sci. 2018, 49, 2044–2053. [Google Scholar]
- Yang, Y.; Kang, N.; Xia, H.; Li, J.; Chen, L.; Qiu, F. Metabolites of protoberberine alkaloids in human urine following oral administration of Coptidis Rhizoma decoction. Planta Med. 2010, 76, 1859–1863. [Google Scholar] [CrossRef]
- Liao, F. Diagnostics of Chinese Medicine, 2nd ed.; People’s Medical Publishing House: Beijing, China, 2013; p. 108. (In Chinese) [Google Scholar]
- Qiao, Y.; Zhang, Y.; Peng, S.; Huo, M.; Li, J.; Cao, Y.; Chen, Z. Property theory of Chinese materia medica: Clinical pharmacodynamics of traditional Chinese medicine. J. Tradit. Chin. Med. Sci. 2022, 9, 7–12. [Google Scholar] [CrossRef]
- Bao, H. The Science of Chinese Materia Medicine, 1st ed.; Chinese Agriculture Press: Beijing, China, 2008. (In Chinese) [Google Scholar]
- Wang, J.; Qiao, M.; Zhou, Y.; Du, H.; Bai, J.; Yuan, W.; Liu, J.; Wang, D.; Hu, Y.; Wu, Y. In vitro synergistic effect of baicalin with azithromycin against Staphylococcus saprophyticus isolated from francolins with ophthalmia. Poult. Sci. 2019, 98, 373–380. [Google Scholar] [CrossRef]
- Xiang, J.Y.; Chi, Y.Y.; Han, J.X.; Xiang, H.; Xie, Q. The Toxicity and Attenuation Methods of Toxic Chinese Materia Medica for its Reasonable Application: A Review. Am. J. Chin. Med. 2020, 49, 41–67. [Google Scholar] [CrossRef]
- Cheng, X.; Cao, Z.; Luo, J.; Hu, R.; Cao, H.; Guo, X.; Xing, C.; Yang, F.; Zhuang, Y.; Hu, G. Baicalin ameliorates APEC-induced intestinal injury in chicks by inhibiting the PI3K/AKT-mediated NF-kappaB signaling pathway. Poult. Sci. 2022, 101, 101572. [Google Scholar] [CrossRef] [PubMed]
- Peng, L.Y.; Shi, H.T.; Tan, Y.R.; Shen, S.Y.; Yi, P.F.; Shen, H.Q.; Fu, B.D. Baicalin inhibits APEC-induced lung injury by regulating gut microbiota and SCFA production. Food Funct. 2021, 12, 12621–12633. [Google Scholar] [CrossRef] [PubMed]
- Wan, F.; Wang, M.; Zhong, R.; Chen, L.; Han, H.; Liu, L.; Zhao, Y.; Lv, H.; Hou, F.; Yi, B.; et al. Supplementation with Chinese Medicinal Plant Extracts from Lonicera hypoglauca and Scutellaria baicalensis Mitigates Colonic Inflammation by Regulating Oxidative Stress and Gut Microbiota in a Colitis Mouse Model. Front. Cell. Infect. Microbiol. 2022, 11, 798052. [Google Scholar] [CrossRef] [PubMed]
- Luo, J.; Dong, B.; Wang, K.; Cai, S.; Liu, T.; Cheng, X.; Lei, D.; Chen, Y.; Li, Y.; Kong, J.; et al. Baicalin inhibits biofilm formation, attenuates the quorum sensing-controlled virulence and enhances Pseudomonas aeruginosa clearance in a mouse peritoneal implant infection model. PLoS ONE 2017, 12, e0176883. [Google Scholar] [CrossRef]
- Luo, J.Y.; Yan, D.; Yang, M.H. Study of the anti-MRSA activity of Rhizoma coptidis by chemical fingerprinting and broth microdilution methods. Chin. J. Nat. Med. 2014, 12, 393–400. [Google Scholar] [CrossRef]
- Mun, S.H.; Joung, D.K.; Kim, Y.S.; Kang, O.H.; Kim, S.B.; Seo, Y.S.; Kim, Y.C.; Lee, D.S.; Shin, D.W.; Kweon, K.T.; et al. Synergistic antibacterial effect of curcumin against methicillin-resistant Staphylococcus aureus. Phytomedicine 2013, 20, 714–718. [Google Scholar] [CrossRef]
- Bhattacharjee, M.K.; Bommareddy, P.K.; DePass, A.L. A Water-Soluble Antibiotic in Rhubarb Stalk Shows an Unusual Pattern of Multiple Zones of Inhibition and Preferentially Kills Slow-Growing Bacteria. Antibiotics 2021, 10, 951. [Google Scholar] [CrossRef]
- Chen, D.C.; Wang, L. Mechanisms of therapeutic effects of rhubarb on gut origin sepsis. Chin. J. Traumatol. 2009, 12, 365–369. [Google Scholar]
- Hu, Y. Traditional Chinese Veterinary Medicine, 1st ed.; Science Press: Beijing, China, 2013. (In Chinese) [Google Scholar]
- M100-S11; Performance Standards for Antimicrobial Susceptibility Testing. Clinical and Laboratory Standards Institute: Wayne, PA, USA, 2018; pp. 34–46.
- Monson, M.S.; Lamont, S.J. Genetic resistance to avian pathogenic Escherichia coli (APEC): Current status and opportunities. Avian Pathol. 2021, 50, 392–401. [Google Scholar] [CrossRef]
- Ghimpeteanu, O.M.; Pogurschi, E.N.; Popa, D.C.; Dragomir, N.; Dragotoiu, T.; Mihai, O.D.; Petcu, C.D. Antibiotic Use in Livestock and Residues in Food-A Public Health Threat: A Review. Foods 2022, 11, 1430. [Google Scholar] [CrossRef]
- Chen, J.; Ying, G.G.; Deng, W.J. Antibiotic Residues in Food: Extraction, Analysis, and Human Health Concerns. J. Agric. Food Chem. 2019, 67, 7569–7586. [Google Scholar] [CrossRef] [PubMed]
- Donoghue, D.J. Antibiotic residues in poultry tissues and eggs: Human health concerns? Poult. Sci. 2003, 82, 618–621. [Google Scholar] [CrossRef] [PubMed]
- Khan, R.U.; Khan, A.; Naz, S.; Ullah, Q.; Laudadio, V.; Tufarelli, V.; Ragni, M. Potential Applications of Moringa oleifera in Poultry Health and Production as Alternative to Antibiotics: A Review. Antibiotics 2021, 10, 1540. [Google Scholar] [CrossRef] [PubMed]
- Khan, R.U.; Fatima, A.; Naz, S.; Ragni, M.; Tarricone, S.; Tufarelli, V. Perspective, Opportunities and Challenges in Using Fennel (Foeniculum vulgare) in Poultry Health and Production as an Eco-Friendly Alternative to Antibiotics: A Review. Antibiotics 2022, 20, 278. [Google Scholar] [CrossRef]
- Zhao, T.; Tang, H.; Xie, L.; Zheng, Y.; Ma, Z.; Sun, Q.; Li, X. Scutellaria baicalensis Georgi. (Lamiaceae): A review of its traditional uses, botany, phytochemistry, pharmacology and toxicology. J. Pharm. Pharmacol. 2019, 71, 1353–1369. [Google Scholar] [CrossRef]
- Zhang, M.; Li, H.; Agyekumwaa, A.K.; Yu, Y.; Xiao, X. Effects of citronellal on growth and enterotoxins production in Staphylococcus aureus ATCC 29213. Toxicon Off. J. Int. Soc. Toxinology 2022, 213, 92–98. [Google Scholar] [CrossRef]
- Shen, W.C.; Wang, X.; Qin, W.T.; Qiu, X.F.; Sun, B.W. Exogenous carbon monoxide suppresses Escherichia coli vitality and improves survival in an Escherichia coli-induced murine sepsis model. Acta Pharm. Sin. 2014, 35, 1566–1576. [Google Scholar] [CrossRef]
- Choi, Y.Y.; Kim, M.H.; Han, J.M.; Hong, J.; Lee, T.H.; Kim, S.H.; Yang, W.M. The anti-inflammatory potential of Cortex Phellodendron in vivo and in vitro: Down-regulation of NO and iNOS through suppression of NF-κB and MAPK activation. Int. Immunopharmacol. 2014, 19, 214–220. [Google Scholar] [CrossRef]
- Saldana, Z.; Erdem, A.L.; Schuller, S.; Okeke, I.N.; Lucas, M.; Sivananthan, A.; Phillips, A.D.; Kaper, J.B.; Puente, J.L.; Giron, J.A. The Escherichia coli common pilus and the bundle-forming pilus act in concert during the formation of localized adherence by enteropathogenic E. coli. J. Bacteriol. 2009, 191, 3451–3461. [Google Scholar] [CrossRef]
- Schletter, J.; Heine, H.; Ulmer, A.J.; Rietschel, E.T. Molecular mechanisms of endotoxin activity. Arch. Microbiol. 1995, 164, 383–389. [Google Scholar] [CrossRef]
- Luo, G.; Zhang, J.; Sun, Y.; Wang, Y.; Wang, H.; Cheng, B.; Shu, Q.; Fang, X. Nanoplatforms for Sepsis Management: Rapid Detection/Warning, Pathogen Elimination and Restoring Immune Homeostasis. Nano-Micro Lett. 2021, 13, 88. [Google Scholar] [CrossRef] [PubMed]
- Holzheimer, R.G. Antibiotic induced endotoxin release and clinical sepsis: A review. J. Chemother. 2001, 13, 159–172. [Google Scholar] [CrossRef]
- Shenep, J.L. Antibiotic-induced bacterial cell lysis: A therapeutic dilemma. Eur. J. Clin. Microbiol. 1986, 5, 11–12. [Google Scholar] [CrossRef] [PubMed]
- Morrison, D.C.; Bucklin, S.E. Evidence for antibiotic-mediated endotoxin release as a contributing factor to lethality in experimental gram-negative sepsis. Scand. J. Infect. Dis. Suppl. 1996, 101, 3–8. [Google Scholar] [PubMed]
- Galanos, C.; Freudenberg, M.A. Mechanisms of endotoxin shock and endotoxin hypersensitivity. Immunobiology 1993, 187, 346–356. [Google Scholar] [CrossRef]
- Schedlowski, M.; Engler, H.; Grigoleit, J.S. Endotoxin-induced experimental systemic inflammation in humans: A model to disentangle immune-to-brain communication. Brain Behav. Immun. 2014, 35, 1–8. [Google Scholar] [CrossRef]
- Seidavi, A.; Tavakoli, M.; Asroosh, F.; Scanes, C.G.; Abd, E.M.; Naiel, M.; Taha, A.E.; Aleya, L.; El-Tarabily, K.A.; Swelum, A.A. Antioxidant and antimicrobial activities of phytonutrients as antibiotic substitutes in poultry feed. Environ. Sci. Pollut. Res. Int. 2022, 29, 5006–5031. [Google Scholar] [CrossRef]
- Qiu, X.; Shen, W.; Wang, X.; Qin, W.; Sun, B. A novel strategy for antimicrobial agent: Role of exogenous carbon monoxide on suppressing Escherichia coli vitality and toxicity. Pak. J. Pharm. Sci. 2015, 28, 281–292. [Google Scholar]
- Wang, G.; Wu, M.; Si, Z. Clinical Observation on Curative Effect of Compound Yujin Powder on Chicken Colibacillosis. Shandong Anim. Husb. Vet. Med. 2003, 3, 9–10. [Google Scholar]
- Xu, Y.; Guo, S.; Chen, G.; Zhang, M.; Zhang, X.; Dou, D. Evaluation of anti-sepsis activity by compounds with high affinity to lipid a from HuanglianJiedu decoction. Immunopharmacol. Immunotoxicol. 2017, 39, 364–370. [Google Scholar] [CrossRef]

| Traditional Chinese Medicine | Medicinal Plant | Medicinal Parts | Voucher Specimen Number | Local Name | Amount (g) | Origin (China) | Effects [17,34] |
|---|---|---|---|---|---|---|---|
| Curcumae radix | Curcuma wenyujin Y.H.Chen et C.Ling | Radix | NJAU-CVM-2018001 | Yu Jin | 30 | Zhejiang province | Promote qi circulation and relieve depression, cool and mix blood, and normalize gallbladder to cure jaundice |
| Chebulae fructus | Terminalia chebula Retz | Fructus | NJAU-CVM-2018002 | He Zi | 15 | Guangzhou province | Restraining intestine to stop diarrhea, astringe the lung to relieve asthma |
| Scutellariae radix | Scutellaria baicalensis Georgi | Radix | NJAU-CVM-2018003 | Huang Qin | 30 | Liaoning province | Clear heat and dry damp, clear away heat and toxic material |
| Rhei radix et rhizoma | Rheum palmatum L. | Radix et Rhizoma | NJAU-CVM-2018004 | Da Huang | 60 | Gansu province | Remove accumulation with purgation, cool the blood and remove the toxic materials |
| Coptids rhizome | Coptis chinensis Franch. | Rhizoma | NJAU-CVM-2018005 | Huang Lian | 30 | Sichuan province | Clear heat and dry damp, clear away heat and toxic material |
| Phellodendri chinensis cortex | Phellodendron Chinese Schneid. | Cortex | NJAU-CVM-2018006 | Huang Bo | 30 | Sichuan province | Clear heat and dry damp, clear away heat and toxic material |
| Gardeniae fructus | Gardenia jasminoides Ellis | Fructus | NJAU-CVM-2018007 | Zhi Zi | 30 | Zhejiang province | Purge fire and remove toxic substance, reduce fever and cause diuresis |
| Paeoniae radix alba | Paeonia lactiflora Pall. | Radix | NJAU-CVM-2018008 | Bai shao | 15 | Zhejiang province | Nourish yin and supplement blood, calm the liver and relieve pain |
| Test or Medium | Isolate H | ATCC25922 | Escherichia coli |
|---|---|---|---|
| TSI response mode | |||
| Indole | + | + | + |
| Methyl Red | + | + | + |
| VP | − | − | − |
| Simmons Citrate | − | − | − |
| Glucose | |||
| Lactose | /− | ||
| Maltose | |||
| Mannitol | + | ||
| Sucrose | V | ||
| H2S | − | − | − |
| Urease | − | − | − |
| Power (semi-solid agar) | + | + | +/− |
| Phenylalanine deaminase | − | − | − |
| Lysine decarboxylase | + | + | V |
| Ornithine decarboxylase | + | + | V |
| Ribitol/Calendula | − | − | −/+ |
| Inositol | − | − | − |
| Sorbitol | − | + | V |
| Melibiose | + | + | + |
| Raffinose | + | − | V |
| Antibiotic | Isolate 1 MDREC | 2 ATCC25922 | ||
|---|---|---|---|---|
| The Diameter of the Inhibitory Bacterium (mm) | Determination of Drug Resistance | The Diameter of the Inhibitory Bacterium (mm) | Determination of Drug Resistance | |
| AMP | 0.0 | 3 R | 18.77 | 4 S |
| AML | 0.0 | R | 23.16 | S |
| CPI | 16.3 | R | 30.88 | S |
| CRO | 12.0 | R | 32.05 | S |
| LEX | 9.1 | R | 22.86 | S |
| CED | 10.5 | R | 21.85 | S |
| GEN | 12.4 | R | 22.90 | S |
| AN | 8.0 | R | 26.77 | S |
| KAN | 13.0 | R | 26.04 | S |
| STR | 11.5 | R | 18.40 | S |
| TET | 0.0 | R | 24.05 | S |
| CIP | 0.0 | R | 29.24 | S |
| LVF | 10.7 | R | 28.12 | S |
| NOR | 0.0 | R | 34.41 | S |
| OFL | 12.6 | R | 26.95 | S |
| SXT | 0.0 | R | 33.61 | S |
| CHL | 0.0 | R | 21.66 | S |
| FOS | 0.0 | R | 38.23 | S |
| SF | 0.0 | R | 25.64 | S |
| MDREC | ATCC25922 | |
|---|---|---|
| YJP | 250.0 | 250.0 |
| Rb | 250.0 | 250.0 |
| SR | 62.5 | 62.5 |
| Bac | 2.0 | 2.0 |
| CIP | 8.0 × 10−2 | 1.0 × 10−5 |
| Group | Sample Number | Survival Number | Survival Rate (%) |
|---|---|---|---|
| BC | 15 | 15 | 100.00 a |
| EC | 15 | 4 | 26.7 d |
| CIP | 15 | 5 | 33.3 cd |
| YJP | 15 | 10 | 66.7 bc |
| SR | 15 | 10 | 66.7 bc |
| Bac | 15 | 11 | 73.3 b |
Disclaimer/Publisher’s Note: The statements, opinions and data contained in all publications are solely those of the individual author(s) and contributor(s) and not of MDPI and/or the editor(s). MDPI and/or the editor(s) disclaim responsibility for any injury to people or property resulting from any ideas, methods, instructions or products referred to in the content. |
© 2023 by the authors. Licensee MDPI, Basel, Switzerland. This article is an open access article distributed under the terms and conditions of the Creative Commons Attribution (CC BY) license (https://creativecommons.org/licenses/by/4.0/).
Share and Cite
Meng, J.; Wang, J.; Zhu, J.; Li, S.; Qiu, T.; Wang, W.; Ding, J.; Wang, W.; Liu, J. Bacteriostatic Effects of Yujin Powder and Its Components on Clinical Isolation of Multidrug-Resistant Avian Pathogenic Escherichia coli. Vet. Sci. 2023, 10, 328. https://doi.org/10.3390/vetsci10050328
Meng J, Wang J, Zhu J, Li S, Qiu T, Wang W, Ding J, Wang W, Liu J. Bacteriostatic Effects of Yujin Powder and Its Components on Clinical Isolation of Multidrug-Resistant Avian Pathogenic Escherichia coli. Veterinary Sciences. 2023; 10(5):328. https://doi.org/10.3390/vetsci10050328
Chicago/Turabian StyleMeng, Jinwu, Jinli Wang, Jinyue Zhu, Siya Li, Tianxin Qiu, Weiran Wang, Jinxue Ding, Wenjia Wang, and Jiaguo Liu. 2023. "Bacteriostatic Effects of Yujin Powder and Its Components on Clinical Isolation of Multidrug-Resistant Avian Pathogenic Escherichia coli" Veterinary Sciences 10, no. 5: 328. https://doi.org/10.3390/vetsci10050328
APA StyleMeng, J., Wang, J., Zhu, J., Li, S., Qiu, T., Wang, W., Ding, J., Wang, W., & Liu, J. (2023). Bacteriostatic Effects of Yujin Powder and Its Components on Clinical Isolation of Multidrug-Resistant Avian Pathogenic Escherichia coli. Veterinary Sciences, 10(5), 328. https://doi.org/10.3390/vetsci10050328
